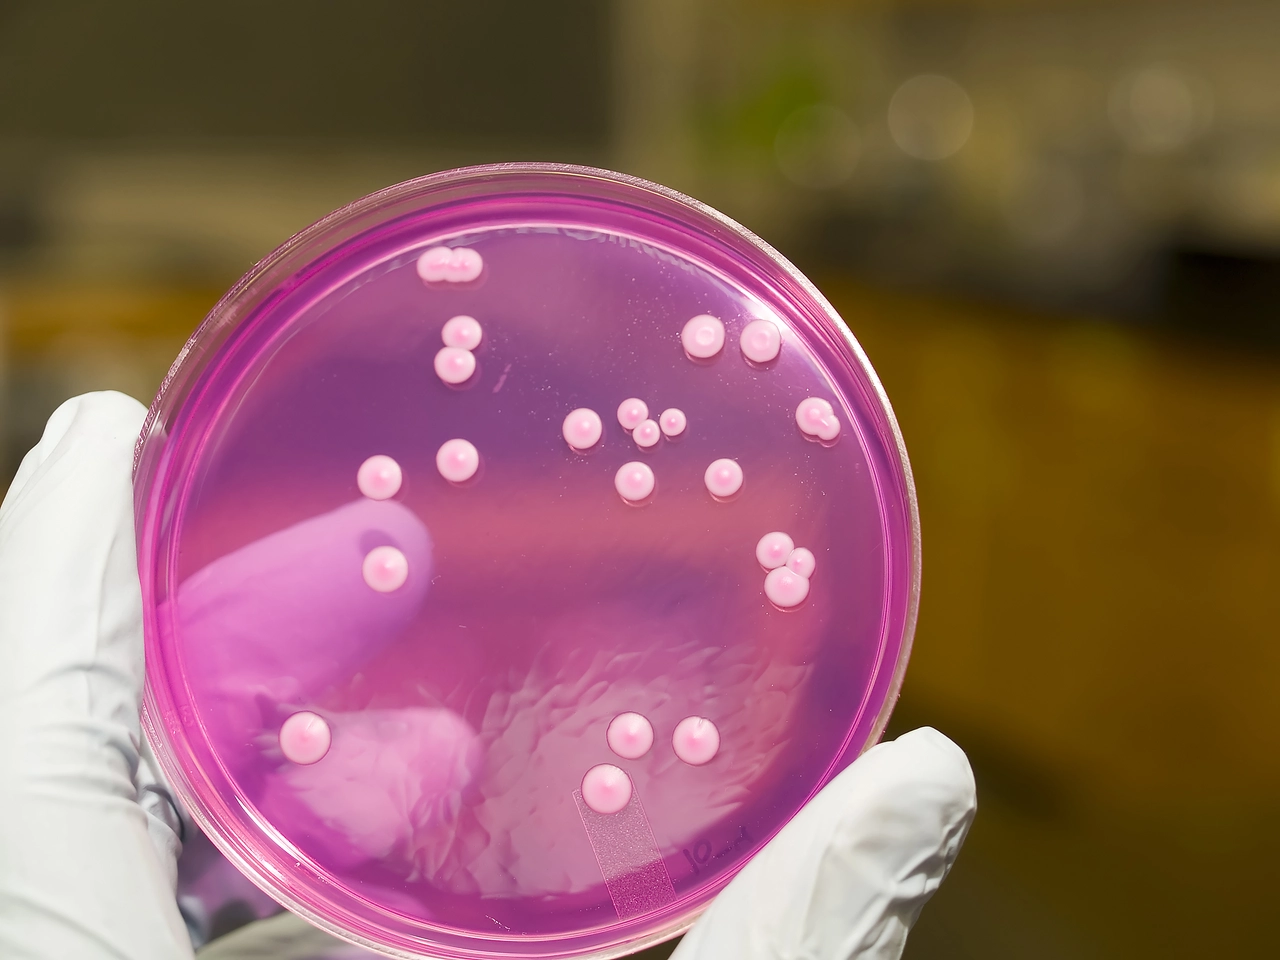
El lugar que nunca limpias y acumula más bacterias que el inodoro: descúbrelo

¿Estás pagando de más o de menos a la limpiadora? Este es el precio justo por hora en 2025
Determinar si estás pagando el precio justo por hora a una limpiadora en 2025 depende de múltiples factores: la región de España, el convenio colectivo aplicable, el tipo de tareas, la experiencia y si el servicio es a través de empresa o individual. Aún así, existen referencias claras y valores medios oficiales que permiten estimar … Read more